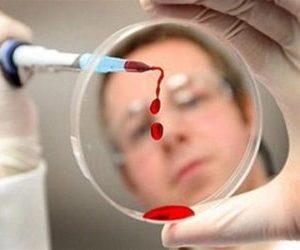
Как лечить свиной грипп

Свиной грипп, вызванный вирусом H1N1, представляет серьезную угрозу для здоровья, особенно во время эпидемий. В статье рассмотрим симптомы и первые признаки заболевания, а также инкубационный период, что поможет распознать болезнь. Также предложим эффективные методы лечения свиного гриппа, чтобы минимизировать риски и ускорить восстановление. Знание этих аспектов важно для диагностики и принятия необходимых мер при заражении.
Что это за болезнь
Классическим временем для распространения эпидемий среди населения считается зимний период. С начала января наблюдается максимальное количество заболевших. Это может быть связано с тем, что в холодное время года организм испытывает дефицит витаминов и солнечного света, что ослабляет иммунную систему и делает её более уязвимой.
Риск заболеть значительно увеличивается во время новогодних праздников. В этот период большинство людей ведут малоподвижный образ жизни, злоупотребляют алкогольными напитками и жирной пищей. Это сопровождается недостатком физической активности и длительным времяпрепровождением на диване перед телевизором. В результате организм оказывается менее способным противостоять серьезным вирусам, и после перенесенной болезни могут возникнуть осложнения.
Одним из эффективных способов предотвратить заболевание является вакцинация. Каждый год вирус претерпевает мутации, однако привитый организм способен самостоятельно справляться с новыми штаммами. Рекомендуется своевременно делать прививки от гриппа, чтобы минимизировать риск заражения свиным гриппом.
Врачи подчеркивают, что лечение свиного гриппа должно быть комплексным и индивидуальным. Основное внимание уделяется симптоматическому лечению: при высокой температуре рекомендуется принимать жаропонижающие средства, такие как парацетамол или ибупрофен. Важно также поддерживать водный баланс, употребляя достаточное количество жидкости. В случаях тяжелого течения заболевания или при наличии сопутствующих заболеваний врачи могут назначить противовирусные препараты, такие как осельтамивир. Специалисты акцентируют внимание на необходимости своевременной вакцинации, которая является наиболее эффективным способом профилактики. Кроме того, врачи советуют соблюдать меры предосторожности, такие как регулярное мытье рук и избегание контактов с больными, чтобы снизить риск заражения.
https://youtube.com/watch?v=bZdzI90-wGo
Симптомы у человека
Вирус штамма H1N1, проникая в организм, обычно вызывает немедленную реакцию иммунной системы. Крайне важно не упустить начало заболевания и своевременно обратиться за профессиональной медицинской помощью. На ранних стадиях болезнь хорошо поддается лечению.
При инфицировании гриппом человек в первую очередь ощущает резкое ухудшение общего состояния. Это может проявляться в виде слабости, подавленного настроения, ломоты в мышцах и костях, а также желания много отдыхать, чтобы облегчить свое состояние.
Затем у пациента со свиным гриппом может резко повыситься температура тела, достигая 39 градусов и выше.
К числу первых симптомов свиного гриппа также относится ноющая головная боль, которая усиливается под воздействием яркого света и громких звуков.
По мере прогрессирования заболевания больной может испытывать одышку и нехватку воздуха. Попытки сделать глубокий вдох не приносят облегчения.
Грипп обычно сопровождается насморком и болями в горле.
Одной из особенностей свиного гриппа является возникновение у пациента тошноты и диареи. Это состояние может привести к серьезному обезвоживанию организма. При появлении этих симптомов необходимо срочно вызвать медицинскую помощь.
| Метод лечения | Описание | Примечания |
|---|---|---|
| Противовирусные препараты | Осельтамивир (Тамифлю), Занамивир (Реленза), Перамивир (Рапиваб), Балоксавир (Ксофлюза) | Эффективны при раннем начале приема (в течение 48 часов после появления симптомов). Назначаются врачом. |
| Симптоматическое лечение | Жаропонижающие (парацетамол, ибупрофен), обезболивающие, средства от кашля, спреи для горла, назальные спреи | Направлено на облегчение симптомов. Дозировка и выбор препаратов зависят от возраста и состояния пациента. |
| Постельный режим | Отдых и минимизация физической активности | Помогает организму сосредоточить силы на борьбе с инфекцией. |
| Обильное питье | Вода, чай, морсы, компоты | Предотвращает обезвоживание, помогает выводить токсины. |
| Увлажнение воздуха | Использование увлажнителя воздуха | Облегчает дыхание, особенно при кашле и заложенности носа. |
| Изоляция | Избегание контактов с другими людьми | Предотвращает распространение вируса. |
| Консультация врача | Обращение к медицинскому специалисту при появлении симптомов | Важно для постановки точного диагноза, назначения адекватного лечения и предотвращения осложнений. |
| Вакцинация | Ежегодная прививка от гриппа | Профилактическая мера, снижающая риск заражения и тяжесть течения заболевания. |
Группы риска
Каждое заболевание имеет свои группы риска. Свиной грипп особенно тяжело переносится следующими категориями людей:
- Беременные женщины.
- Женщины, которые кормят грудью.
- Дети дошкольного возраста.
- Пожилые люди.
- Лица с хроническими заболеваниями.
- Люди, страдающие от заболеваний сердечно-сосудистой системы.
При появлении первых симптомов гриппа представителям этих групп следует незамедлительно обратиться к врачу, чтобы предотвратить возможные осложнения.
https://youtube.com/watch?v=tRG1bEJN3Qk
Инкубационный период свиного гриппа
Инкубационный период заболевания представляет собой время от момента, когда вирус гриппа попадает в организм, до появления первых явных симптомов. Для свиного гриппа этот период составляет от 24 часов до 3 дней. В редких случаях инкубационный период может продлиться до недели.
Лечение свиного гриппа
Пациентов в первую очередь интересует, как правильно лечить свиной грипп.
Для того чтобы установить тип вируса, необходимо пройти полное обследование организма. Это включает в себя анализ крови и другие диагностические процедуры. Только после точной диагностики врач сможет назначить соответствующее лечение.
Медикаментозная терапия должна подбираться индивидуально для каждого пациента с учетом его уникальных особенностей. Специалист выберет препараты, которые эффективно воздействуют на вирус гриппа.
Самостоятельное лечение может привести к тому, что возбудители инфекции станут устойчивыми к лекарственным средствам, что может вызвать серьезные осложнения. Чтобы избежать этого, следует принимать только те медикаменты, которые назначил врач.
Важно. Необходимо соблюдать постельный режим, употреблять больше теплых напитков и строго следовать всем рекомендациям врача.
Осложнения свиного гриппа
При отсутствии своевременного лечения существует риск возникновения серьезных осложнений. Одним из таких осложнений является пневмония, которая требует продолжительного и сложного процесса лечения.
К числу других возможных осложнений относятся менингит, воспаление трахеи и гайморит. В особенно запущенных случаях грипп может затронуть сердечную мышцу, что приводит к развитию миокардита у пациента.
Полезные советы
При повышении температуры у пациента не стоит спешить с её снижением. Организм, изменяя терморегуляцию, активно борется с инфекцией, и вмешательство в этот естественный процесс может быть нежелательным.
Узнайте, как эффективно лечить кашель при гриппе.
Беспокоиться следует, если температура поднимается до очень высоких значений. При достижении отметки в 39 градусов это состояние может привести к серьезным осложнениям. В таком случае допустимо принять жаропонижающее средство.
Необходимо вызвать скорую помощь, если температура не снижается в течение нескольких часов после приема лекарства. Важно запомнить, когда именно началось повышение температуры, и сообщить эту информацию медицинским работникам.
Профилактика заболевания
Чтобы избежать заражения гриппом, важно укреплять иммунную систему. На её функционирование оказывает влияние здоровый образ жизни. Следует внимательно относиться к своему питанию, обеспечивать полноценный сон и регулярно заниматься физической активностью.
В холодное время года стоит включить в свой рацион следующие продукты:
- Кисломолочные изделия (кефир, ряженка, натуральный йогурт).
- Специи (имбирь, корица, куркума и другие пряности).
- Ягоды и фрукты, богатые витамином C (цитрусовые, клубника).
Для укрепления иммунитета полезны витаминные морсы, которые можно готовить из шиповника, клюквы, брусники и других ягод.
Как лечить грипп во время беременности?
Узнайте о мерах профилактики ОРВИ и гриппа.
Сбалансированное питание невозможно без белковых продуктов. В рацион можно включать нежирное мясо птицы и кролика. Один раз в неделю стоит устраивать рыбный ужин. Полезный белок также содержится в яичных белках и обезжиренном твороге.
Во время эпидемий инфекционных заболеваний рекомендуется сократить потребление сахара, так как считается, что глюкоза способствует размножению вирусов.
Если в вашем городе объявлена эпидемия гриппа, лучше избегать мест с большим количеством людей. После поездок в общественном транспорте рекомендуется использовать антибактериальные салфетки, пропитанные спиртом.
Дома и на работе стоит применять мыло с антибактериальным эффектом и регулярно мыть руки.
Свиной вирус гриппа может передаваться воздушно-капельным путём. Для предотвращения заражения полезно использовать одноразовые медицинские маски, которые следует менять каждые 3 часа.
В качестве профилактического средства можно также промывать носовую полость слабым раствором соли.
Важно. В период распространения гриппа необходимо часто проветривать помещения и регулярно проводить влажную уборку с использованием антисептических моющих средств.
Заключение
Знание симптомов и методов лечения свиного гриппа у людей имеет огромное значение, поскольку ранняя медицинская помощь может спасти жизнь пациента. При грамотном и комплексном подходе к терапии гриппа уменьшается риск возникновения осложнений.
https://youtube.com/watch?v=Zbs0bVFXlww
Диагностика свиного гриппа
Диагностика свиного гриппа начинается с оценки клинических симптомов, которые могут включать высокую температуру, кашель, боль в горле, мышечные боли, головную боль, усталость и, в некоторых случаях, рвоту или диарею. Важно отметить, что симптомы свиного гриппа могут быть схожи с симптомами обычного гриппа или других респираторных заболеваний, что делает диагностику более сложной.
Для точной диагностики свиного гриппа врачи могут использовать несколько методов:
- Клинический осмотр: Врач проводит осмотр пациента, собирает анамнез, уточняет наличие контактов с больными людьми или животными, а также выясняет, были ли поездки в регионы с высоким уровнем заболеваемости.
- Лабораторные тесты: Для подтверждения диагноза могут быть назначены специальные тесты, такие как ПЦР (полимеразная цепная реакция), которые позволяют выявить вирус в образцах из носоглотки или других биологических жидкостях. Также могут использоваться серологические тесты для определения наличия антител к вирусу.
- Дифференциальная диагностика: Важно исключить другие заболевания с похожими симптомами, такие как обычный грипп, COVID-19, пневмония и другие респираторные инфекции. Для этого могут потребоваться дополнительные анализы и исследования.
Раннее выявление свиного гриппа имеет ключевое значение для эффективного лечения и предотвращения распространения вируса. Если у вас есть подозрения на свиной грипп, важно обратиться к врачу, который сможет провести необходимые исследования и назначить соответствующее лечение.
Кроме того, в некоторых случаях может потребоваться госпитализация, особенно для людей с высоким риском осложнений, таких как пожилые люди, беременные женщины и лица с хроническими заболеваниями. В таких ситуациях врачи могут проводить более углубленное обследование и мониторинг состояния пациента.
Вакцинация против свиного гриппа
Вакцинация является одним из самых эффективных способов профилактики свиного гриппа, который вызывается вирусом H1N1. Вакцины против свиного гриппа разрабатываются с учетом особенностей вируса и его возможных мутаций, что позволяет обеспечить защиту от наиболее распространенных штаммов.
Существует несколько типов вакцин, которые могут быть использованы для защиты от свиного гриппа. Наиболее распространенные из них — это инактивированные вакцины, которые содержат убитые вирусы, и живые аттенуированные вакцины, которые содержат ослабленные вирусы. Оба типа вакцин стимулируют иммунный ответ организма, что позволяет ему быстрее и эффективнее справляться с инфекцией в случае заражения.
Вакцинация рекомендуется для всех групп населения, особенно для тех, кто находится в группе риска. К группе риска относятся: дети до 5 лет, пожилые люди старше 65 лет, беременные женщины, а также люди с хроническими заболеваниями, такими как астма, диабет, заболевания сердца и легких. Эти категории населения более подвержены тяжелым формам заболевания и осложнениям, поэтому вакцинация для них особенно важна.
Вакцинация обычно проводится в осенний период, когда начинается сезон гриппа. Важно помнить, что вакцинация не только защищает индивидуально каждого человека, но и способствует формированию коллективного иммунитета, что снижает распространение вируса в обществе.
После вакцинации может наблюдаться легкая реакция организма, такая как покраснение или болезненность в месте инъекции, а также общие симптомы, такие как головная боль или легкая лихорадка. Эти реакции обычно проходят в течение нескольких дней и являются нормальной реакцией на введение вакцины.
Важно отметить, что вакцинация не гарантирует 100% защиту от свиного гриппа, но значительно снижает риск заболевания и его тяжесть. Поэтому даже после вакцинации рекомендуется соблюдать меры предосторожности, такие как регулярное мытье рук, избегание контактов с больными и использование масок в общественных местах во время эпидемий.
Для получения вакцины необходимо обратиться в медицинское учреждение, где проводятся вакцинации. В некоторых странах вакцинация может быть бесплатной для определенных групп населения, в то время как в других случаях может потребоваться оплата. Перед вакцинацией рекомендуется проконсультироваться с врачом, чтобы выяснить возможные противопоказания и получить рекомендации по вакцинации.
Рекомендации по уходу за больными
Уход за больными свиным гриппом требует особого внимания и заботы, так как это заболевание может вызывать серьезные осложнения, особенно у людей с ослабленным иммунитетом, пожилых людей и детей. Вот несколько рекомендаций, которые помогут обеспечить правильный уход за пациентами с этим вирусом.
1. Обеспечение покоя и комфорта: Больным свиным гриппом необходимо обеспечить спокойную обстановку. Постельный режим поможет организму сосредоточиться на борьбе с инфекцией. Убедитесь, что пациент находится в хорошо проветриваемом помещении, но без сквозняков. Комфортная температура и влажность воздуха также способствуют улучшению самочувствия.
2. Поддержка гидратации: Важно следить за тем, чтобы пациент получал достаточное количество жидкости. Вода, травяные чаи, бульоны и соки помогут предотвратить обезвоживание, которое может возникнуть из-за высокой температуры и потери жидкости. Избегайте кофеина и алкоголя, так как они могут усугубить обезвоживание.
3. Контроль температуры: Регулярно измеряйте температуру тела пациента. Если температура превышает 38°C, можно использовать жаропонижающие средства, такие как парацетамол или ибупрофен, но только по рекомендации врача. Следите за состоянием пациента и при необходимости обращайтесь за медицинской помощью.
4. Симптоматическое лечение: Для облегчения симптомов, таких как кашель, боль в горле и головная боль, можно использовать безрецептурные препараты. Однако перед их применением обязательно проконсультируйтесь с врачом, чтобы избежать возможных противопоказаний.
5. Соблюдение гигиенических мер: Чтобы предотвратить распространение вируса, необходимо соблюдать строгие правила гигиены. Регулярно мойте руки с мылом и водой, особенно после контакта с больным. Используйте одноразовые платки для носа и рта, а также дезинфицируйте поверхности, с которыми контактирует пациент.
6. Наблюдение за состоянием: Следите за изменениями в состоянии здоровья пациента. Если наблюдаются ухудшения, такие как затрудненное дыхание, сильная боль в груди, спутанность сознания или высокая температура, немедленно обращайтесь за медицинской помощью.
7. Психологическая поддержка: Заболевание может вызывать у пациента тревогу и стресс. Важно поддерживать моральный дух больного, общаться с ним, предлагать развлечения и отвлечения, чтобы снизить уровень стресса и улучшить общее самочувствие.
Следуя этим рекомендациям, вы сможете обеспечить качественный уход за больными свиным гриппом и помочь им быстрее восстановиться. Не забывайте, что при любых сомнениях или ухудшении состояния здоровья необходимо обращаться к медицинским специалистам.